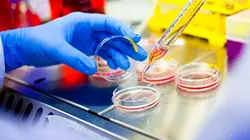
Visuel de Affaire Maëlys : l'ombre d'un prédateur

2019
Comment supprimer la publicité ?
TV-PROGRAMME.COM nécessite une équipe complète pour fonctionner, évoluer et rester gratuit pour tous.
La publicité contribue aujourd’hui à financer ce service et à rémunérer les personnes qui le font vivre.
En vous abonnant, vous profitez du service sans publicité tout en soutenant plus directement TV-PROGRAMME.COM.
Je supprime la publicitéLouis-Mathieu Nivôse est principalement connu(e) pour ses fonctions de réalisateur sur Dossiers criminels, réalisateur sur Le Paris souterrain, tout un monde, réalisateur sur Affaire Maëlys : l'ombre d'un prédateur.
Comment supprimer la publicité ?
TV-PROGRAMME.COM nécessite une équipe complète pour fonctionner, évoluer et rester gratuit pour tous.
La publicité contribue aujourd’hui à financer ce service et à rémunérer les personnes qui le font vivre.
En vous abonnant, vous profitez du service sans publicité tout en soutenant plus directement TV-PROGRAMME.COM.
Je supprime la publicité
Vos avis sur Louis-Mathieu Nivôse